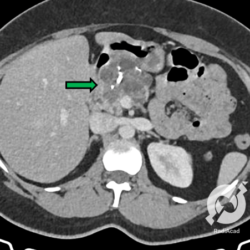

Facomatoses

Paciente sabidamente portador de neurofibromatose tipo I, realizou tomografia computadorizada para acompanhamento da doença, que demonstrou alguns nódulos subcutâneos homogêneos, pequenos e com densidade de partes moles (setas), relacionados a neurofibromas.

Ressonância magnética de um paciente portador de neurofibromatose tipo I. A imagem ponderada em T2 com saturação de gordura mostra uma grande lesão subcutânea com extensão à cavidade pélvica através do canal inguinal, exibindo hipersinal, que corresponde a um neurofibroma plexiforme, que correspondem a lesões de nervos periféricos mais extensas e são patognomônicos de NF-I.

Como muitas facomatoses, na neurofibromatose também existe a inativação de um gene supressor tumoral e por isso é frequente o desenvolvimento de neoplasias. Neste caso, temos uma ressonância magnética de abdome, com cortes axiais ponderados em T2, com saturação de gordura, no qual identificamos uma grande lesão expansiva na adrenal esquerda, de contornos regulares e bem definidos, apresentando hipersinal heterogêneo, que embora não seja o achado mais clássico de intenso hipersinal em T2, corresponde a um feocromocitoma.

Caso “florido” de um paciente com NF-I. A tomografia mostra vários nódulos subcutâneos difusos (setas amarelas) e uma imagem típica de um neurofibroma (ou Schwanomma. São indistinguíveis por exames de imagem, mas em casos de NF-I o mais comum é o neurofibroma) centrado em um forame de conjugação lombar à direita com o clássico aspecto de halteres que o caracteriza (seta vermelha). Observa-se ainda uma lesão expansiva retroperitoneal levemente hipoatenuante, lobulada e bem delimitada, projetando-se à direita da linha média. A hipótese levantada foi de uma lesão de linhagem sarcomatosa.

Paciente portador de neurofibromatose apareceu no serviço de pronto atendimento com queixa de tosse e febre (sim, eles também podem ter pneumonias como qualquer pessoa normal). Os pulmões são normais, mas podemos identificar imagens nodulares claramente extrapulmonares esparsas (setas azuis) possivelmente cutâneas, mas não podendo excluir nódulos intercostais. Se observarmos com atenção, na parede lateral do hemitórax esquerdo, observa-se um discreto nódulo cutâneo (seta vermelha). E pensar que é “apenas” uma radiografia simples...

Paciente com NF-I, observamos neste corte de RM ponderado em T2 com saturação de gordura uma imagem nodular bem delimitada junto ao músculo psoas direito, com leve hipersinal e que representa um neurofibroma.

Tomografia computadorizada de tórax mostrando um nódulo subcostal à esquerda, que corresponde a um neurofibroma.

Corte de tomografia computadorizada ao nível da pelve mostrando vários nódulos subcutâneos difusos, predominando na região glútea esquerda (setas vermelhas) que correspondem a neurofibromas e o mesmo tipo de lesão comprometendo os diversos forames sacrais identificados, que se encontram bastante alargados.

Pequenas imagens nodulares no delgado com forte captação de contraste na fase arterial do estudo tomográfico de abdome, relacionadas a pequenos tumores carcinoides em um paciente com NF-I.

Aqui um paciente com uma imagem nodular extra-axial temporal esquerda, com forte impregnação homogênea pelo meio de contraste, correspondente a um meningioma (seta azul). Observamos ainda uma lesão igualmente extra-axial no ângulo pontocerebelar do mesmo lado, com tênue captação do contraste, relacionada a um provável Schwanomma (seta vermelha). Este paciente é portador de neurofibromatose tipo II e embora não possamos determinar o tipo histológico, na NF-II o mais comum é a ocorrência de Schwanommas.

Paciente portador de neurofibromatose tipo II, realizou uma ressonância magnética encefálica que mostrou, no corte axial ponderado em T1 após a infusão de contraste endovenoso, na fossa posterior, duas lesões extra-axiais bem delimitadas, com forte impregnação homogênea pelo agente paramagnético, uma no ângulo pontocerebelar, possivelmente um Schwanomma (seta azul) e a outra posteriormente devendo corresponder a um meningioma (seta vermelha). Na imagem coronal, igualmente ponderada em T1 com infusão de contraste endovenoso, observamos uma grande lesão extra-axial, com impregnação homogênea pelo contraste, que corresponde a um meningioma. Interessante notar um sinal clássico que mostra porque a lesão é extra-axial: existe uma compressão da substância cinzenta lateral e inferiormente ao tumor, sem infiltração, já que está contido pela meninge.

Paciente portador de neurofibromatose tipo II, realizou uma ressonância magnética encefálica que mostrou, no corte axial ponderado em T1 após a infusão de contraste endovenoso, na fossa posterior, duas lesões extra-axiais bem delimitadas, com forte impregnação homogênea pelo agente paramagnético, uma no ângulo pontocerebelar, possivelmente um Schwanomma (seta azul) e a outra posteriormente devendo corresponder a um meningioma (seta vermelha). Na imagem coronal, igualmente ponderada em T1 com infusão de contraste endovenoso, observamos uma grande lesão extra-axial, com impregnação homogênea pelo contraste, que corresponde a um meningioma. Interessante notar um sinal clássico que mostra porque a lesão é extra-axial: existe uma compressão da substância cinzenta lateral e inferiormente ao tumor, sem infiltração, já que está contido pela meninge.

A Síndrome de Sturge Weber tem praticamente um achado, que são estas calcificações serpiginosas occipitais, que são na verdade sequela de uma isquemia ocorrida no início da vida destes indivíduos. A isquemia ocorre porque na síndrome de Sturge Weber ocorre uma angiomatose leptomeníngea que acaba favorecendo estes eventos isquêmicos. Se repararem bem, existe uma redução volumétrica do parênquima cerebral adjacente, com proeminência do espaço subaracnoide e do corno temporal do ventrículo lateral.

Calcificações alongadas no hemisfério cerebral direito características da síndrome de Sturge Weber. Observa-se também uma calcificação contralateral com a mesma etiologia. Neste caso, não existe uma atrofia cortical associada.

Tomografia cranioencefálica com janela óssea para mostrar bem as calcificações da síndrome de Sturge Weber. Este achado é visto praticamente apenas nesta condição

Alterações típicas da síndrome de Sturge Weber no lobo parietal esquerdo com sinais de atrofia dos giros corticais contíguos.

O principal achado na doença de Von Hippel Lindau é o hemangioblastoma, tumor de fossa posterior cístico, com componente sólido que sofre intenso realce pelo contraste. Aqui vemos uma ressonância magnética de um paciente com Von Hippel Lindau que mostra o tumor na sua forma típica, localizado no hemisfério cerebelar esquerdo.

Uma das características da doença de Von Hippel Lindau é o aparecimento de cistos, sendo o pâncreas um dos órgão envolvidos. Aqui, vemos diversas pequenas imagens císticas homogêneas, com paredes finas e bem delimitadas, difusas no corpo e cauda pancreáticos.

Assim como outras facomatoses, a doença de VHL também promove mutações em genes supressores tumorais, portanto neoplasias são frequentes. Neste paciente observamos uma grande lesão expansiva na loja da adrenal esquerda, de contornos regulares e atenuação heterogênea, apresentando componentes de partes moles e liquefeitos, bem como com calcificações de permeio. Com estas características pensamos em feocromocitoma de adrenal, tumor frequente na doença de VHL.

Este é um paciente com VHL e rim em ferradura, nenhuma relação entre as duas condições. Observamos um cisto no polo superior do rim esquerdo, este sim frequente na doença de VHL, mas chama a atenção uma lesão expansiva heterogênea, com centro liquefeito, na porção horizontal do rim, que claramente corresponde a uma neoplasia, comum em casos da doença de Von Hippel Lindau.